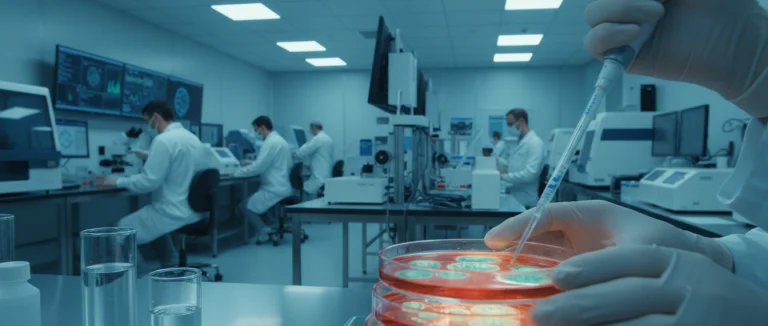
Лаборатория, где выращивают стволовые клетки

iPSC: лечение в Лив Хоспитал – новые возможности терапии
-
Что такое индуцированные плюрипотентные стволовые клетки?
-
Как создаются iPSC в лаборатории?
-
Применение iPSC в медицине и в Лив Хоспитал
-
Преимущества и ограничения iPSC‑терапии
-
Процедуры в Лив Хоспитал: от консультации до восстановления
-
Почему выбирают Лив Хоспитал
В последние годы индуцированные плюрипотентные стволовые клетки (iPSC) стали одной из самых обсуждаемых тем в биомедицинских исследованиях. Эти клетки способны дифференцироваться во все типы тканей организма, открывая новые горизонты для регенеративной медицины, моделирования заболеваний и персонализированных лекарств. По данным международных исследований, более 30 клинических испытаний уже используют iPSC, и их число стремительно растет.
Для иностранных пациентов, ищущих передовые методы лечения, Лив Хоспитал предлагает программы, основанные на технологиях стволовых клеток, включая терапию iPSC. В статье мы разберём, что такое индуцированные плюрипотентные стволовые клетки, как их получают, какие применения уже реализованы и какие преимущества они дают пациентам.
Мы также расскажем о том, как проходит процесс лечения в Лив Хоспитал, от первой консультации до полного восстановления, и почему стоит доверять именно этой аккредитованной группе больниц.
Что такое индуцированные плюрипотентные стволовые клетки?
Индуцированные плюрипотентные стволовые клетки – это клетки, полученные пере программированием взрослых соматических клеток в состояние, аналогичное эмбриональным стволовым клеткам. В 2006 году японский ученый Шинья Яманака впервые продемонстрировал, что введение четырёх факторов (Oct4, Sox2, Klf4 и c-Myc) в зрелые клетки позволяет им «вернуться» к плюрипотентному состоянию. С тех пор технология была усовершенствована, и сейчас iPSC создаются из кожи, крови или мочевого эпителия пациента.
Ключевые особенности iPSC:
- Плюрипотентность – способность дифференцироваться в любой тип клеток организма.
- Автологичность – клетки получаются из собственного организма пациента, что минимизирует риск отторжения.
- Этичность – отсутствие необходимости использования эмбриональных стволовых клеток.
Сравнительная таблица основных различий между iPSC и эмбриональными стволовыми клетками (ESC):
| Характеристика | iPSC | ESC |
|---|---|---|
| Источник | Взрослые соматические клетки | Эмбрионы (5‑7‑дневные) |
| Этичность | Этично приемлемо | Этические споры |
| Риск иммунного отторжения | Низкий (автологичный) | Высокий (аллогенный) |
| Трудности получения | Требует пере программирования | Требует эмбрионов |
Как создаются iPSC в лаборатории?
Процесс получения индуцированных плюрипотентных стволовых клеток состоит из нескольких этапов, каждый из которых требует строгого контроля качества. Ниже перечислены основные шаги:
- Отбор биопсии (кожа, кровь, моча) от пациента.
- Изоляция и культивирование соматических клеток в специальной среде.
- Введение факторов Яманака (Oct4, Sox2, Klf4, c‑Myc) с помощью векторов (вирусные, плазмидные, mRNA).
- Отбор колоний, демонстрирующих плюрипотентность, и их расширение.
- Проверка качества: генетический скрининг, тесты на кариотип, оценка способности к дифференциации.
Существует несколько методов доставки факторов:
| Метод | Преимущества | Недостатки |
|---|---|---|
| Вирусные векторы (Retrovirus, Lentivirus) | Высокая эффективность трансдукции | Риск интеграции в геном |
| Эпизомные плазмиды | Неинтегрирующие, безопаснее | Низкая эффективность |
| mRNA‑трансфер | Отсутствие геномной интеграции, быстрый процесс | Требует повторных трансфекций |
| Протеиновые факторы | Минимальный генетический риск | Сложность производства и доставки |
В Лив Хоспитал используется комбинация эпизомных плазмид и mRNA‑технологий, что обеспечивает высокий уровень безопасности и эффективности при получении iPSC для последующей терапии.

Применение iPSC в медицине и в Лив Хоспитал
Индуцированные плюрипотентные стволовые клетки находят применение в нескольких ключевых областях:
- Регенеративная терапия: восстановление повреждённой ткани сердца, печени, нервной системы.
- Моделирование заболеваний: создание «органоидов» для изучения патогенеза рака, нейродегенеративных болезней.
- Персонализированная фармакология: тестирование лекарств на клетках пациента, снижение риска побочных эффектов.
- Генная терапия: коррекция генетических дефектов в iPSC с последующей трансплантацией.
В Лив Хоспитал уже реализованы несколько клинических программ, основанных на iPSC:
| Программа | Цель | Этапы лечения |
|---|---|---|
| Терапия сердечной недостаточности | Восстановление миокарда после инфаркта | Создание кардиомиоцитов из iPSC → Трансплантация → Реабилитация |
| Лечение паркинсонизма | Замещение погибших дофаминергических нейронов | Дифференциация в нейроны → Трансплантация в субстанцию nigra → Нейрореабилитация |
| Регенерация печени при циррозе | Восстановление функции гепатоцитов | Создание гепатоцитов из iPSC → Инъекция в печень → Мониторинг функций |
Каждая программа сопровождается тщательным мониторингом, включая МРТ, биохимический скрининг и оценку качества жизни пациента. Благодаря международной аккредитации JCI, Лив Хоспитал гарантирует соответствие самым высоким стандартам безопасности.

Преимущества и ограничения iPSC‑терапии
Как и любая инновационная технология, iPSC имеет свои сильные и слабые стороны. Ниже представлены ключевые преимущества и ограничения.
| Преимущества | Ограничения |
|---|---|
| Автологичность → минимальный риск отторжения | Трудоемкость производства → высокая стоимость |
| Этичность → отсутствие эмбриональных клеток | Риск генетических аномалий при репрограммировании |
| Гибкость дифференциации → широкий спектр тканей | Необходимость длительного наблюдения за пациентами |
| Персонализированный подход → адаптация под конкретного пациента | Ограниченные данные о долгосрочной безопасности |
В Лив Хоспитал каждый случай рассматривается индивидуально, чтобы минимизировать риски и обеспечить максимальную эффективность лечения.
Процедуры в Лив Хоспитал: от консультации до восстановления
Для иностранных пациентов процесс лечения iPSC в Лив Хоспитал построен таким образом, чтобы обеспечить комфорт и полную прозрачность.
- Первичная онлайн‑консультация – обсуждение медицинской истории, целей лечения и предварительная оценка возможности iPSC‑терапии.
- Подготовка биопсии – организация сдачи образцов (кровь, кожа) в удобном для пациента месте.
- Лабораторное пере программирование – производство iPSC в сертифицированных лабораториях.
- Дифференциация и проверка качества – создание нужного типа клеток и их тестирование.
- Трансплантация – проведение процедуры в условиях операционной JCI‑аккредитации.
- Реабилитация и наблюдение – постоперационный уход, физиотерапия, регулярные обследования.
- Поддержка после выписки – помощь в организации проживания, трансфера и последующего медицинского сопровождения.
Все этапы сопровождаются профессиональными переводчиками, транспортом из аэропорта и помощью в поиске жилья, что делает процесс максимально удобным для международных пациентов.
Почему выбирают Лив Хоспитал
Лив Хоспитал – это частная группа больниц в Стамбуле, аккредитованная JCI, специализирующаяся на передовых методах лечения, включая терапию стволовыми клетками. Мы предоставляем комплексные услуги для иностранных пациентов: запись на приём, трансфер, переводчики и поддержка в размещении. Высокий уровень медицинской экспертизы, современное оборудование и индивидуальный подход делают нас надёжным партнёром в поиске инновационных решений для здоровья.
Готовы узнать, как индуцированные плюрипотентные стволовые клетки могут изменить вашу жизнь? Свяжитесь с нашими специалистами уже сегодня, чтобы получить персональную консультацию и подобрать оптимальную программу лечения.
Запишитесь на онлайн‑приём, и мы поможем организовать всё необходимое – от трансфера до проживания в Стамбуле.
Часто задаваемые вопросы
Индуцированные плюрипотентные стволовые клетки (iPSC) получаются из соматических клеток пациента (кожа, кровь, моча) путём введения факторов Яманака – Oct4, Sox2, Klf4 и c‑Myc. После пере программирования клетки приобретают свойства, аналогичные эмбриональным стволовым клеткам, но без использования эмбрионов, что делает технологию этичной. iPSC способны дифференцироваться в любые типы клеток, что открывает возможности для регенеративной медицины, моделирования заболеваний и персонализированных лекарств.
Главные различия между iPSC и ESC заключаются в источнике и этических аспектах. iPSC создаются из собственных соматических клеток пациента, что минимизирует риск иммунного отторжения и делает процесс этически приемлемым. ESC получают из ранних эмбрионов (5‑7‑дневных), что вызывает этические дебаты. По плюрипотентности обе типы способны дифференцировать в любые ткани, однако iPSC требуют более сложного процесса пере программирования, тогда как ESC доступны напрямую из эмбрионов.
Для создания iPSC в Лив Хоспитал используют неинтегрирующие эпизомные плазмиды, которые не встраиваются в геном, а также mRNA‑трансфер, позволяющий быстро вводить факторы без риска геномной интеграции. Такой комбинированный подход обеспечивает высокий уровень безопасности, снижает риск генетических аномалий и сохраняет эффективность пере программирования, что особенно важно для клинических применений.
Лив Хоспитал реализует несколько программ на основе iPSC: 1) Терапия сердечной недостаточности – дифференциация iPSC в кардиомиоциты и их трансплантация для восстановления миокарда после инфаркта. 2) Лечение паркинсонизма – создание дофаминергических нейронов из iPSC и их внедрение в субстанцию nigra. 3) Регенерация печени при циррозе – получение гепатоцитов из iPSC и их инъекция в печень. Все программы сопровождаются тщательным мониторингом (МРТ, биохимический скрининг) и соответствуют международным стандартам JCI.
Плюсы iPSC‑терапии включают автологичность, что снижает риск отторжения, отсутствие этических проблем, связанных с эмбриональными клетками, и возможность дифференцировать клетки в широкий спектр тканей для разных заболеваний. Ограничения состоят в сложном и дорогом процессе производства, риске генетических аномалий при пере программировании, необходимости длительного наблюдения за пациентами и ограниченных данных о долгосрочной безопасности и эффективности терапии.
* Содержимое нашего сайта предназначено только для информационных целей. Обязательно обратитесь к врачу для диагностики и лечения. В содержание страницы не включены элементы, содержащие информацию о терапевтических медицинских услугах в Лив Госпитале.